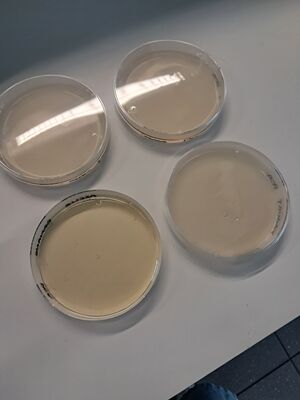

Art Sciences 2025/2026 E7
Projet :
Un cochon vaut plus qu’un rat mais moins qu’un chien. Un malinois vaut plus qu’un bâtard mais moins qu’un bouvier bernois. chacun de ces animaux, même tous réunis, valent bien moins qu’un seul d’entre nous. En Attelage, un ou des animaux non-humains tirent un élément conduit par un humain. Pour ce faire, il faut des “bêtes” performantes, musclées et comment les contrôler autrement qu’avec leurs propres qualités : le cuir. Un cuir de Vache pour soumettre les Bœufs. Un animal mort sur un animal vivant. A la manière du jambon industriel, les animaux non-humains d’attelages portent sur eux plusieurs identités. C’est un mélange, une nécropole mouvante. Nombre d’artistes se sont questionnés et se questionnent encore sur ces notions. Je pense notamment à Maurizio Cattelan et Berlinde de Bruyckere. A ma façon, je me suis demandé comment la vie pourrait reprendre forme à partir de ce cuir produit pour l’équitation ou l’attelage ou même les laisses pour chien. Pour Jardin sur le nécropole, j'aimerais développer ensemble un exemple de moisissure, de pourriture ou du moins de bactéries qui grandiraient visiblement sur ce cuir récupéré au préalable. Ainsi, cette matière domestiquée redeviendrait sauvage. La forme recherchée est celle d'une “peau de bête” reconstituée et tissée de différents filets, sangles, gourmettes, etc... Celle-ci serait posée sur un tréteau en bois assez simple mais très présent dans les selleries pour y poser les selles des chevaux. Le cuir de ce projet est de seconde main uniquement.
Workshop
Mardi 27/01 :
Cette journée nous a permis de discuter et de déterminer les aliments qu'on utilisera pour effectuer les tests de moisissure sur le cuir ainsi que sur une gélose PCA afin de pouvoir comparer les deux "support" pour le développement de la moisissure. La gélose PCA n'est pas sélective c'est-à-dire qu'elle fait donc pousser tous les microorganismes (bactéries, levures, champignons = moisissure). Les aliments choisis sont : la purée de banane, du yaourt, de l'agar agar, et des colorants alimentaire pour tester si la moisissure pouvait être colorée, car Axelle souhaite avoir plusieurs teintes de moisissure pour son projet.
Mercredi 28/01 :
La matinée nous a permis de réaliser les essais.
Dans des boites de pétris, nous avons placés séparément :
- Gélose + banane
- Gélose + yaourt lait de vache
- Gélose + yaourt lait de vache + colorants alimentaires rose, jaune, violet (séparés)
- Gélose + agar agar gélifié + colorants alimentaires rose, jaune, violet (séparés)
- Cuir + banane
- Cuir + yaourt lait de vache
- Cuir + yaourt lait de vache + colorants alimentaires rose, jaune, violet (séparés)
- Cuir + agar agar gélifié + colorants alimentaires rose, jaune, violet (séparés)
Jeudi 29/01:
La matinée à permis de regarder les boîtes, nous avons observé une différence minime : banane brunit sur gélose et cuir, légers points blancs sur l'agar agar + gélose.
Réalisation du début du tissage à partir d'un filet pour cheval de trait, d'une selle de centre équestre et d'un collier pour l'agriculture (bœuf ou cheval).